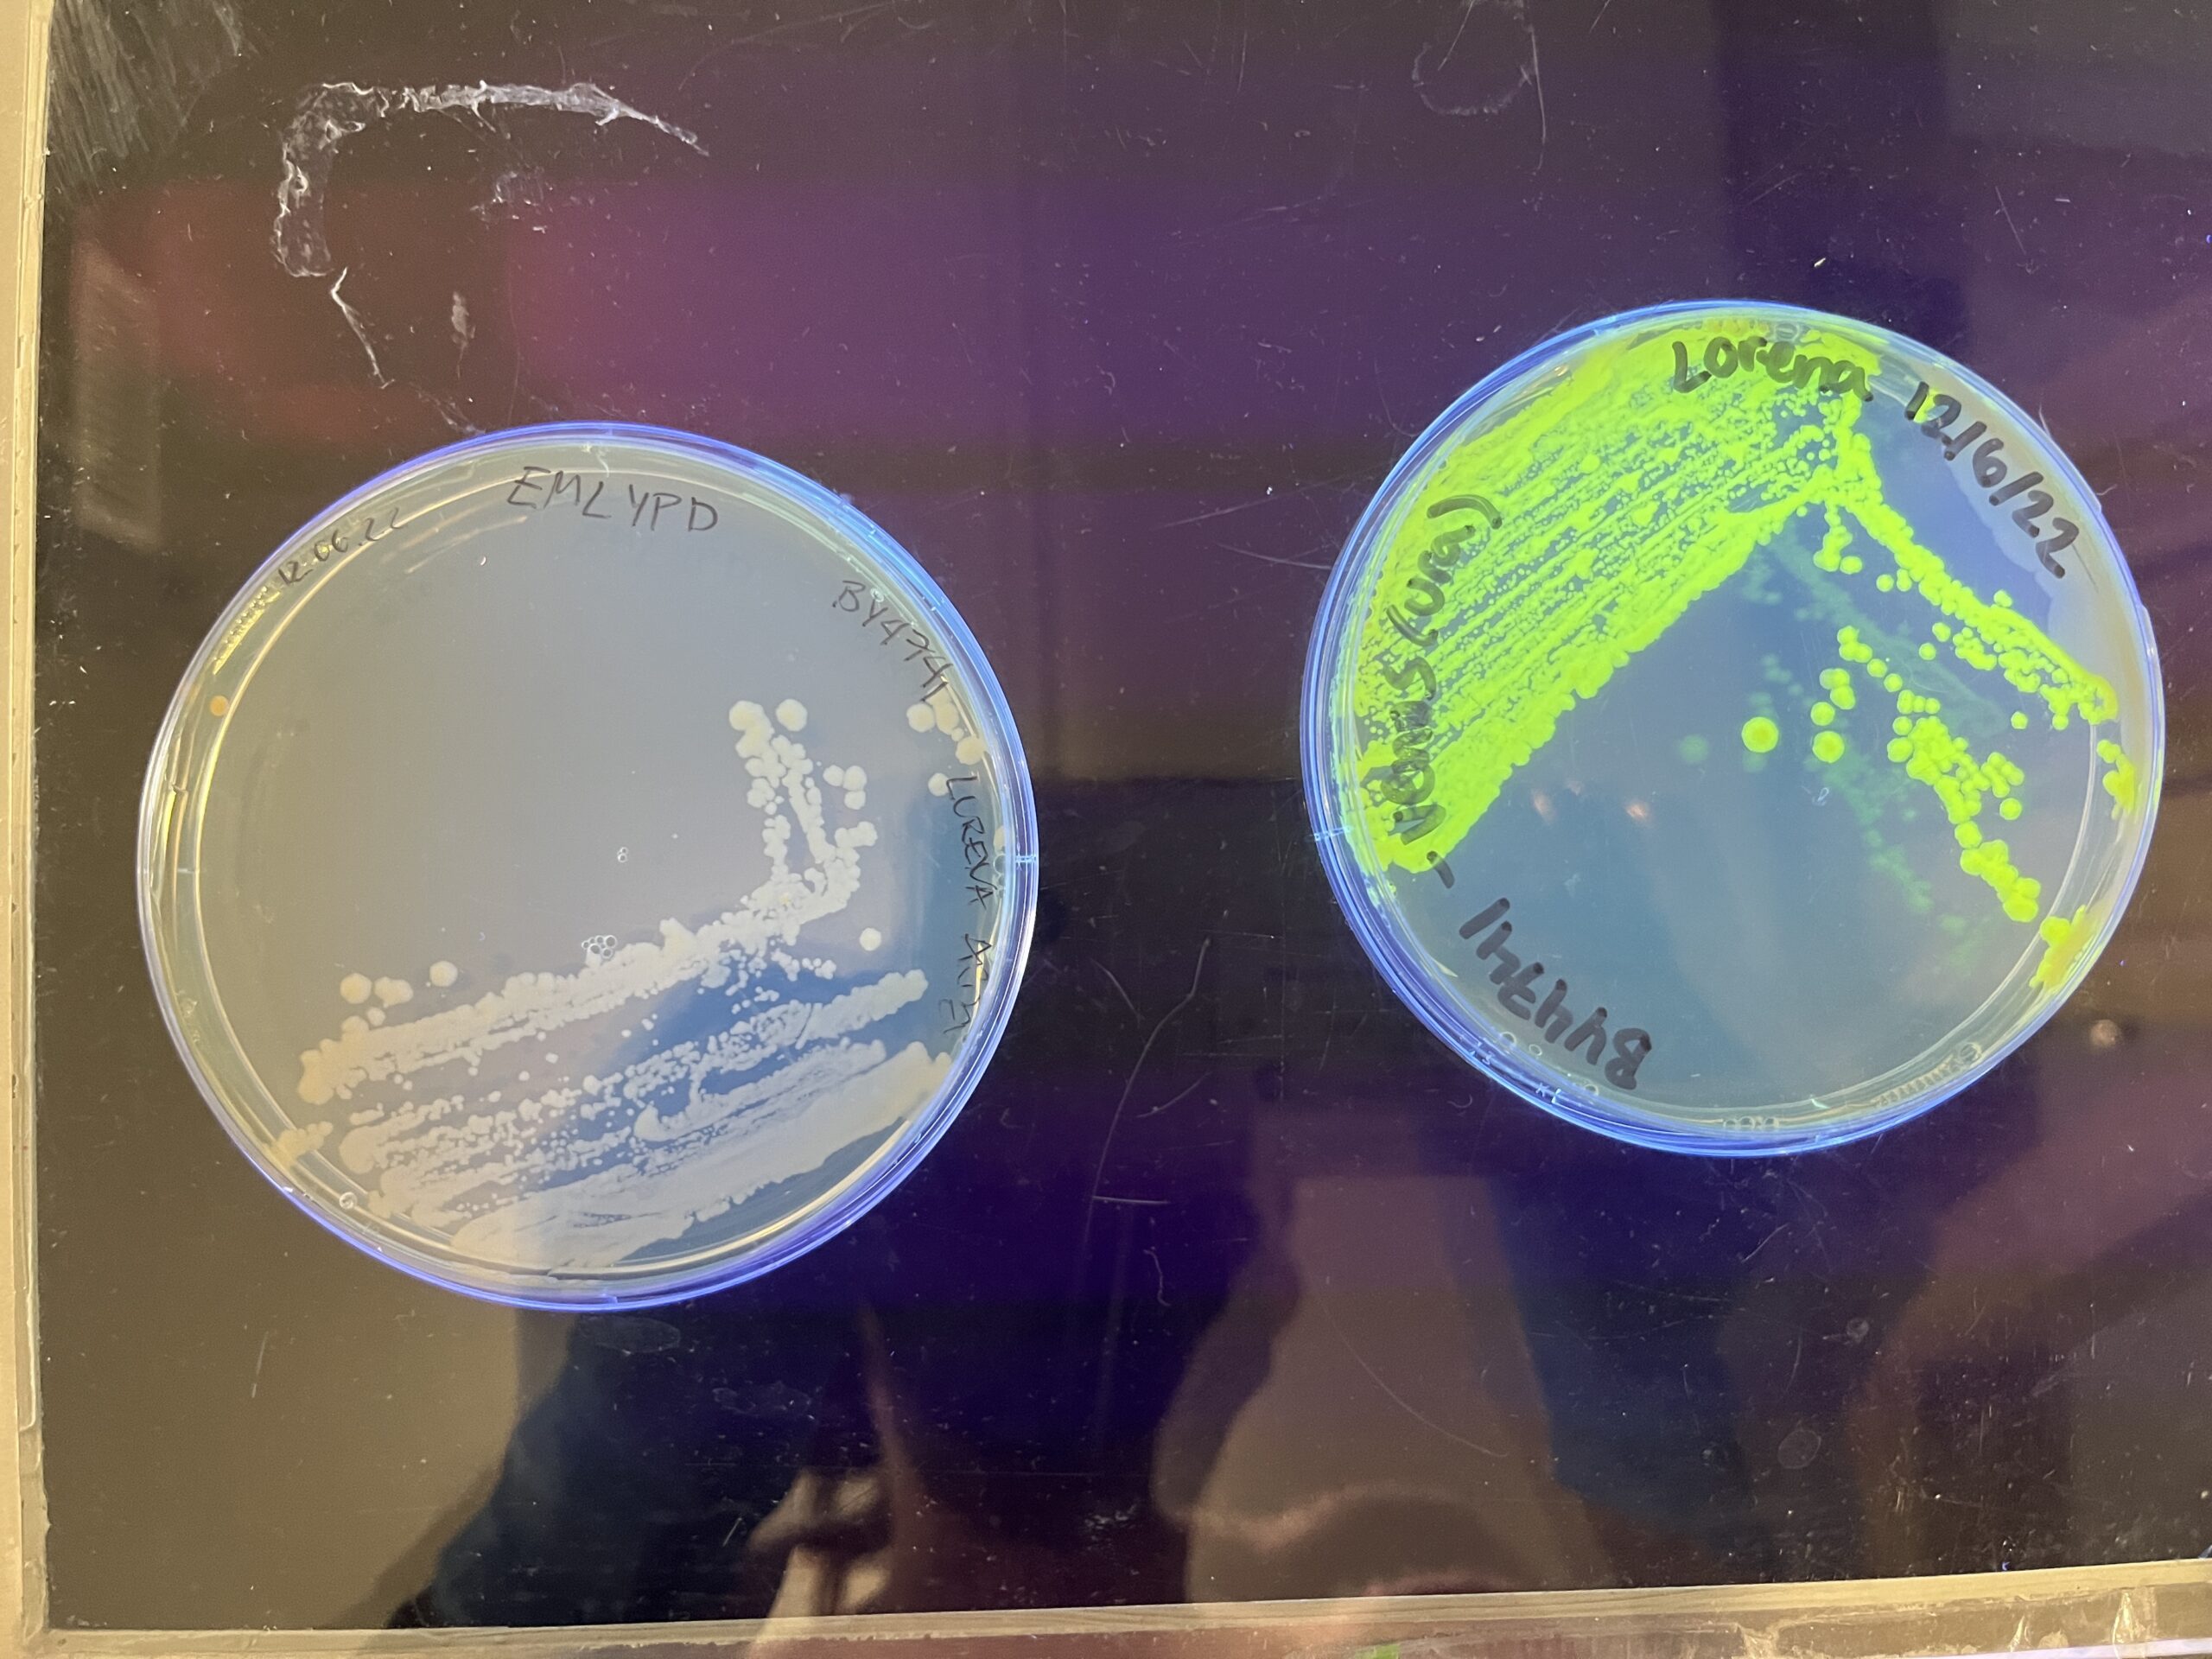

Abstract
When people are asked about genetically engineered living materials, most imagine a creature similar to Frankenstein or an ill-intentioned scientist. But what if bio-engineered materials solved real world problems such as cutting down supply chain issues, provide light to rural communities without electricity or detect environmental pollutants?
For my thesis I focused on a special group of microbes called Synscoby, a material developed by MIT & The Imperial College of London and the good it could do for the world, if the world only knew more about it.
My aim is to give a larger audience a first insight into this new exciting technology in a fun yet informative way. By utilizing my art background and marrying it with the science, I am creating an immersive installation in collaboration with Genspace, the world’s first community biology lab.
For my thesis I cultured Synscoby, a living material that is created in a process inspired by the fermented beverage kombucha.
Other than this being a world, what makes Synscoby special is that it has been bio-engineered to respond to light and water pollutants. This means it could be used as lighting source among many other applications.
Research
SCOBY (Symbiotic, culture of bacteria and yeast), a living organism, a colony of beneficial bacteria and yeast that work together to ferment water, tea and sugar into a tangy, slightly effervescent beverage called kombucha
Most kombucha fermentation starts with a Cellulose mat and liquid that houses the bacteria and yeast. These cultures are often passed down from batch to batch, and can be used to start new fermentations.
When microbes are in a favorable environment they produced a microbial mat found floating at the container’s air liquid interface the microbes grow it to protect themselves and their environment
Bacterial cellulose is a water-soluble polymers and is mainly composed of carbohydrates and proteins. They require proper care and feeding to remain healthy and active, such as regular feeding with sugar and tea, and proper storage at a suitable temperature.
Synscoby
In a process inspired by the fermented beverage kombucha, the researchers from MIT and The Imperial college of London were able to produce cellulose embedded with enzymes that can perform a variety of functions, such as sensing environmental pollutants or responding to light.
Similar to a kombucha mother, it is a tough cellulose material that researchers say can be used to purify water and detect pollutants. They envision Syn-SCOBY being used in the biomedical field and for food applications.
Most of the wild yeast strains used for fermentation are difficult to genetically modify, so the researchers replaced them with a strain of laboratory yeast called Saccharomyces cerevisiae. They combined the yeast with a type of bacteria called Komagataeibacter rhaeticus, which their collaborators at Imperial College London had previously isolated from a kombucha mother. This species can produce large quantities of cellulose.
Because the researchers used a laboratory strain of yeast, they could engineer the cells to do any of the things that lab yeast can do — for example, producing enzymes that glow in the dark, or sensing pollutants in the environment. The yeast can also be programmed so that they can break down pollutants after detecting them.
“We foresee a future where diverse materials could be grown at home or in local production facilities, using biology rather than resource-intensive centralized manufacturing,” says Timothy Lu, an MIT associate professor of electrical engineering and computer science and of biological engineering.
Technical Details